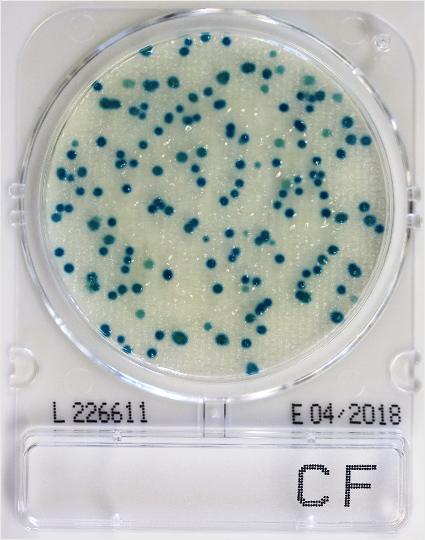
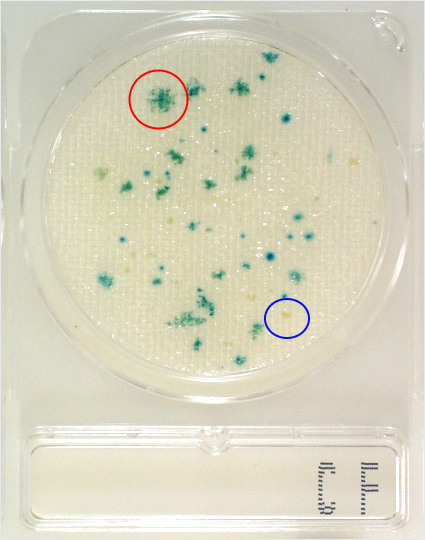
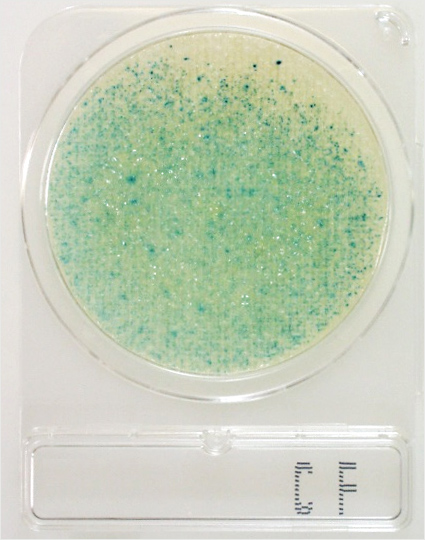
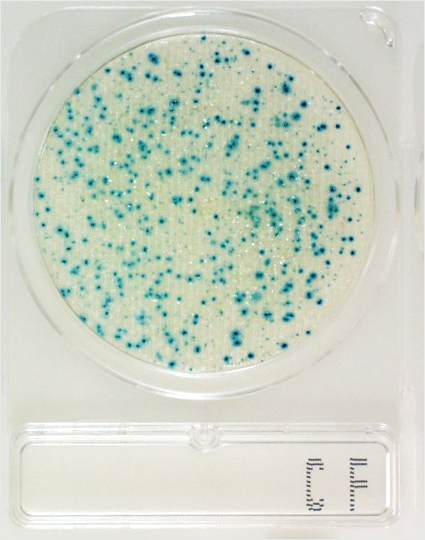
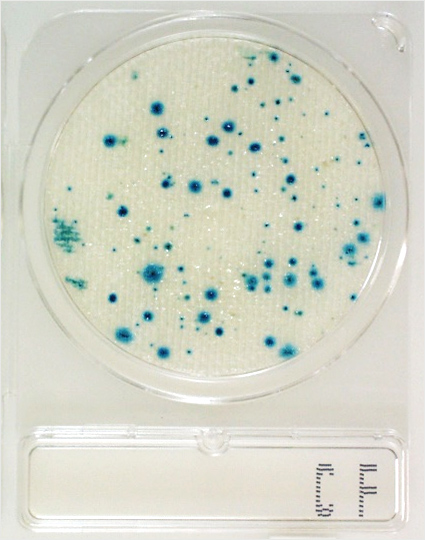
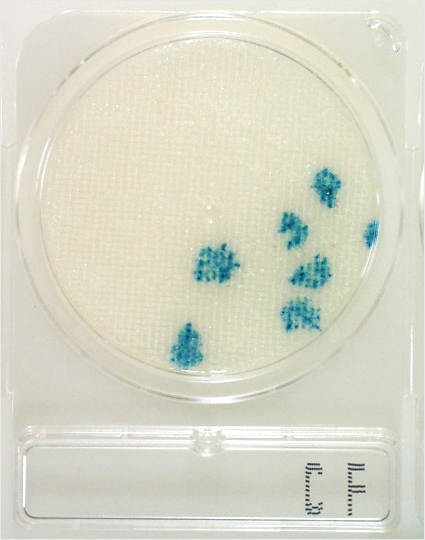

コンパクトドライ™ 判定ガイドコンパクトドライ™ CF
本ガイドは、コンパクトドライ™ CFの培養結果について適切に理解していただくためのものです。その他の製品については以下をご参照ください。
コンパクトドライ™ CF
| 用途 | 大腸菌群数測定用 |
|---|---|
| CF | Coliform Count |
| 認証 | 食品衛生検査指針2018収載/AOAC-PTM認証/MicroVal認証/NordVal認証 |
| 特長 | ・発色酵素基質X-GALにより、コロニーが発色するので、測定が簡単 |
| 判定方法 | 培養温度 35±1℃ 培養時間 24±2時間 大腸菌群:青色~青緑色コロニー |
※大腸菌群はβ-ガラクトシダーゼにより、酵素基質X-GAL(5-ブロモ-4-クロロ-3-インドリル-β-D-ガラクトピラノシド)を分解して青色色素を生成し、青色~青緑色コロニーを形成します。その他の多くの細菌は発育を抑制されるか、発育しても白色コロニーを形成します(グラム陰性桿菌など)。
コロニーの発色・形による判定方法

A 大腸菌群は酵素基質のX-GALの反応で青色または青緑色に発色しますので、これは大腸菌群と判定します。
A 濃い緑色のコロニーは大腸菌群です。確認のためには、コロニーを釣菌し大腸菌群が鑑別できるような培地(デソキシコレート培地など)に接種し確認するのも一つの方法です。

A これは大腸菌群以外の菌 (P. aeruginosa = 緑膿菌)が発育した例です。大腸菌群はコンパクトドライ CFのX-GALと反応し、青色~青緑色のコロニーを形成しますが、それ以外の菌は無色のコロニーを形成します。
A 正円形にピンポイント状に発色しているもの、発色が広がっているもの、これらも大腸菌群として判定してください。
A 黄色いコロニーは、菌自体の色と思われます。X-GALによる青色発色ではないため、計測からは除いてください。
希釈による判定の改善

ポイント
菌数が10,000個/プレートを超えるとコロニーが形成されず、シート全体が発色してしまいます。また、検体の影響によっても判定が困難になることもありますので、これら場合、検体をさらに10倍希釈して検査し、複数の希釈段階を観察すると判定しやすくなります。

A 中心の青い部分は接種した試料の跡です。バナナケーキのような粘度の高い検体を接種した場合、試料液がプレート全体に拡散しません。その周辺にみられるやや広がった青いコロニーは大腸菌群としてカウントしてください。さらに10倍希釈して検査するとコロニーは明瞭になり判定しやすくなります。

A この発色が動物のレバーが持つ酵素によるものなのか、TNTCによる発色なのかは判断できません。このような場合には、検体を更に希釈して検査し、検体の影響を減じてコロニーの発育が見られるかを確認してください。

ヨーグルト 10倍希釈
A ヨーグルトには乳酸菌が108 CFU/g程度含まれており、乳酸菌からのβ-ガラクトシダーゼがシート全体を発色させたと考えられます。


